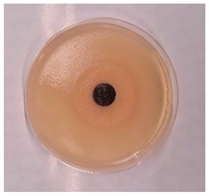
Processes 13 00662 i008

Abstract
The article presents the results of developing carbon-silicon sorbents that demonstrate high efficiency in capturing various types of dust particles, along with partial antibacterial activity. Dust particles ranging from 0.65 to 150 microns were effectively retained by the sorbent, with organic dust capture efficiency varying between 74% and 98%, making these sorbents suitable for air purification in highly polluted indoor environments. The antibacterial activity was tested on Bacillus paramycoides and Pseudomonas koreensis strains using the diffusion method on a solid nutrient medium. Testing showed that sorbent samples with different concentrations of the active ingredient exhibited varying degrees of bacterial growth suppression, with Sample No. 2 demonstrating the highest activity. Optimizing the sorbent composition and increasing the concentration of active components may enhance its antibacterial properties. These sorbents hold great potential for use in air purification systems with additional protection against bacterial contamination, making them promising for environments with high standards for air hygiene and cleanliness.
1. Introduction
Air filters made from plant-based materials represent a promising avenue for ad-dressing air pollution due to their environmental friendliness, efficiency, and affordability. With increasing industrial activity and urbanization, air pollution has become a significant environmental and public health concern. Developing sustainable air filtration technologies is essential to mitigate the harmful impacts of pollutants on human health and the environment. This study explores the potential of plant-based materials as effective, eco-friendly alternatives to synthetic air filters, emphasizing their natural properties and benefits [1].
Plant-based materials are particularly attractive for air filtration because they possess inherent characteristics that make them effective for both mechanical and chemical filtration. For instance, porous structures derived from materials such as activated carbon from coconut shells can trap gases and chemical pollutants, while fiber-based filters can capture particulate matter such as dust and allergens. Unlike synthetic materials, plant-based alternatives are biodegradable, renewable, and energy-efficient to produce, contributing to reduced waste and carbon emissions [2,3].
The necessity of this research lies in the urgent need for innovative air filtration solutions that align with sustainability goals. Current air filter technologies often rely on syn-thetic components that are energy-intensive to produce and contribute to long-term environmental waste. By leveraging plant materials, this study aims to address these challenges while promoting circular economy principles and supporting local agricultural industries.
The air of the atmosphere always contains various impurities, which are classified as physical, mechanical, and biological air pollutants. Mechanical pollutants include solid particles characterized by abrasive properties: lead, dust, mercury, as well as solid particles of different sizes and compositions. In particular, mechanical impurities of atmospheric air are formed in the processes of combustion of organic fuel, in the construction industry, in the mining sector, during underground work, and they are formed for many different reasons [1,2,3,4].
Physical factors of air pollution are associated with the impact of artificial sources; thermal, noise, electromagnetic and radioactive radiation can also be attributed to physical factors. Biological pollution includes the reproduction of microorganisms as a result of anthropogenic activity. Different types of pollution differ in their impact and properties. Toxic substances in the atmospheric air include CO (carbon monoxide), NOx (nitrogen oxides), SO2 (sulfur dioxide), dust particles, and various hydrocarbons [5,6,7].
Taking into account toxicity, prevalence, and hazard, pollutants are classified into groups: the main (criterion) substances polluting the atmosphere are photochemical oxidants, hydrocarbons, sulfur dioxide, nitrogen oxides, carbon monoxide, solid particles, aromatic polycyclic hydrocarbons (PAH), pesticides, permanent gases (fluorochloro-mehanes, carbon dioxide, etc.), and pollutants that have a wide range of effects on living organisms (aldehydes, ozone, polychlorinated biphenyls (PCBs), nitrates, nitrosamines, sulfates, etc.) [8,9].
With the expansion of industrial activities, the development of the construction industry and production, and the deepening of mineral extraction facilities, the requirements for sanitary and technological air purity have increased significantly, which was the result of the development of updated standards and other documents [10,11,12,13].
The hypothesis guiding this research is that air filters developed from plant-based materials will demonstrate comparable or superior efficiency to synthetic filters in removing various air pollutants, while also being more sustainable and cost-effective. To test this hypothesis, the study examines the effectiveness of plant-derived filters against key atmospheric pollutants, including particulate matter, toxic gases, and biological contaminants [1].
Furthermore, the study acknowledges the evolving standards for air quality and filtration efficiency, such as the European EN 1822:2009 standards, and aims to position plant-based filters as viable solutions to meet these stringent criteria. This re-search also addresses specific challenges, such as limited ventilation in underground mining, metro systems, and tunnel construction, where pathogens and hazardous pollutants pose significant risks to human health [14].
In underground mining, metro, and tunnel construction, where ventilation is limited, the risk of airborne pathogens—including those responsible for dangerous and highly infectious diseases—poses a significant challenge [15]. Ensuring the biological safety of workers remains a pressing concern, necessitating continuous improvements in existing technologies and the development of innovative filtration solutions [16].
To address these issues, effective ventilation and advanced filter materials are crucial for producing highly efficient antibacterial air purification systems. Currently, air filtration technologies rely on fine-fiber materials, such as ultra-thin glass and synthetic fibers, metal ceramics, and basalt superfine fibers (0.1–0.4 μm). These materials offer high filtration efficiency, but ongoing research aims to enhance performance, sustainability, and cost-effectiveness [17,18].
One promising alternative is the use of plant-based air filters, which leverage natural materials like rice husk to effectively capture airborne pollutants. Due to its high porosity and large surface area, rice husk serves as an excellent precursor for activated carbon, widely employed in air filtration systems to adsorb chemical pollutants, toxic gases, and odors. The activation process involves pyrolysis—heating the material in the absence of oxygen—followed by steam treatment to further enhance its adsorption capacity [19].
A promising technique for fabricating air purification filters is the extrusion method, which produces multi-channel filters from carbonized rice husk. After undergoing high-temperature carbonization, the husk transforms into a porous carbonaceous material. It is then ground to a uniform particle size and mixed with binders to ensure structural integrity. The resulting mixture is extruded through a matrix containing multiple parallel channels, maximizing the contact surface area for pollutant removal. These filters exhibit both high porosity and mechanical stability, making them suitable for applications ranging from household air purification to industrial-scale air filtration [20].
To introduce antibacterial properties, the filters can be impregnated with antimicrobial agents such as iodine or Lugol’s solution. These compounds possess strong antiseptic properties, effectively eliminating bacteria, viruses, and fungi upon contact. Lugol’s solution, a stabilized mixture of iodine and potassium iodide, enhances iodine’s solubility and retention within the porous filter structure, ensuring prolonged antibacterial activity. As air passes through the filter, microorganisms are exposed to the iodine-saturated surface, leading to their destruction [21].
While iodine is a highly effective disinfectant, its application in enclosed or poorly ventilated environments raises concerns regarding potential toxicity. Prolonged exposure to iodine vapors or aerosols can lead to respiratory irritation and, in severe cases, thyroid dysfunction due to excessive iodine absorption. Occupational safety guidelines established by organizations such as OSHA and NIOSH emphasize the importance of proper ventilation and personal protective equipment (PPE) when handling iodine-based disinfectants. Failure to adhere to these guidelines may pose health risks to workers and occupants [22].
Despite these concerns, the integration of iodine-based antimicrobial treatments significantly enhances the performance of carbonized rice husk filters in air purification. Impregnation, spraying, or encapsulation techniques can enable controlled release of antimicrobial agents, extending the filter’s service life. This environmentally friendly and cost-effective approach leverages renewable resources to create efficient air filtration systems for various applications [23].
Beyond rice husk-based filters, alternative air filtration technologies are emerging. One promising method involves carbon nanofibers engineered to mimic the size of bacteria and viruses, enhancing the capture of airborne contaminants [24]. However, it remains uncertain whether this approach is as effective against actual microorganisms as it is in particle modeling. In contrast, Park et al. demonstrated that incorporating carbon nanotubes into glass fiber filters significantly reduces viral survival upon contact, achieving a 90% reduction in virus viability and substantially outperforming silver nanoparticle-based filtration technologies [25].
While these advanced materials may require entirely new filtration systems, existing filters can also be upgraded with biocidal treatments. For instance, Kim et al. modified HEPA filters with tannic acid, increasing their capture efficiency against the H1N1 virus to approximately 90%, compared to standard HEPA filters [26,27].
In this study, we take a different approach by enhancing conventional filtration technologies through the development of plant-based air filters. This strategy not only offers an eco-friendly alternative to synthetic filters but also contributes to reducing the carbon footprint, promoting sustainable resource use, and creating economic opportunities for local farmers and producers. Ultimately, our research provides valuable insights into the design and application of plant-based air filters, paving the way for their widespread adoption in industrial and domestic settings.
2. Materials and Methods
2.1. Carbonization of Rice Husk
Carbonization is the first process, and it usually involves the formation of a carbon-silicon-containing sorbent by pyrolysis of the feedstock in the temperature range of 600–900 °C in an inert atmosphere (usually nitrogen). The main objective of carbonization is to remove highly volatile components, maximize the specific content of carbon and silicon, and obtain a material with a sufficiently large specific surface area and porosity.
Activation is the second process, and it involves contacting the carbon material with oxidizing gases, such as CO2 or water vapor, in the temperature range of 600–1200 °C, which leads to the removal of more disordered carbon and the formation of a well-developed porous structure [20].
The processes of carbonization and activation of the feedstock ensure the formation of the necessary structural and physicochemical properties in the final products. The synthesis was carried out by carbonization and activation of plant materials in a specially made furnace at temperatures from 300 to 1000 °C for 30–90 min without air access in a carbon dioxide atmosphere. Figure 1 demonstrate a pilot plant for obtaining carbonizates from plant raw materials (5 kg per hour).

Figure 1.
Raw materials (rice husk) and finished products.
The reactor is designed for the sequential dehydration of the initial plant material, accompanied by its depolymerization and partial decomposition in the temperature range from 650 to 800 °C and accompanied by the removal of water (up to 280 °C), and decarboxylation with the formation of pyrolysis resins with a combination of dehydration and decarbonylation processes in the temperature range from 650 °C to 800 °C. The reactor is manufactured according to the order from heat-resistant stainless steel grade 9X18N1T. Figure 2 shows the reactor for carbonization of rice husks [19].

Figure 2.
Carbonization reactor with screw conveyor, heater and individual electric drive of screw conveyor.
The pyrolyzer is a three-meter stainless steel pipe with a screw along the entire length of the reactor and process windows equipped with flanges.
The raw material for the production of carbon-silicon containing sorbents is agricultural processing waste—rice husk (RH).
With an increase in the activation temperature, the volumes of meso- and macropores increase significantly, and this dependence is almost linear in all cases, and the shares of these volumes in the activators are almost the same. The specific surface of the samples obtained by physical activation in the presence of CO2 (activation time 1 h) was found by the thermal desorption method; The highest values of the specific surface are observed at 700 °C; above this temperature, sintering of the sample occurs and, as a result, a decrease in the specific surface.
2.2. Experimental Setup
The test design of carbon-silicon sorbents (CS) was assembled on a two-chamber container, fixed from organic glass, with a total volume of 25 × 21 × 15 cm3. Then, 10% Iodine was taken as an antibacterial component [28].
The design scheme is shown in Figure 3. The front wall is made of sheet polypropylene, where round samples of substrates from a carbon-silicon substrate with a diameter of 44 mm and a thickness of 1 cm were fixed in round holes of the front wall. The diameter of the linear-through pores of the CS is about 0.5–5.0 μm. There are 9 such substrates in total [29].

Figure 3.
Design of the air flow test bench for carbon-silicon sorbents.
The design consists of two blocks; the first block contains a power supply for the fan. The fan is connected to a DC source, and its power is provided by an AC source with a voltage of 220 V. The output voltages and currents of the current source and the fan coincide and are U~12 V, I~0.7 A, respectively.
The first block provides an active flow of air atmosphere through the fan air duct to the second block. The second block is equipped with coarse and fine filters; to impart antibacterial properties to those filters, an antibacterial agent is placed in a special container, then uses a low-frequency mini-generator to emit chlorhexidine in the form of steam into the second block’s volume. Under air pressure, the antibacterial agent flow enters the samples of carbon-silicon sorbent, where viruses and bacterial micro-objects are impregnated in narrow membranes and cell walls of the mesoporous structure of carbon-silicon samples.
At the outlet, after passing from the CS, the impregnated air masses of antibacterial agent solution are distributed as a spray of antiviral and antibacterial substance to protect against infectious viruses, microbes, and bacteria. Thus, sorbents with sizes of 0.5–5.0 μm prevent the penetration of bacteria and viruses to the outside, which allows harmful and dangerous bacteria to be removed from the air. This device can also be used as a disinfectant for home and household purposes; to do so, another disinfectant can be used instead of the antibacterial agent in the second block.
2.3. Model for Everyday Use
The disadvantage of this model is that a relatively large part of the purified air passes through the side surface of the filter element; to reduce this effect, a miniature model of a carbon-silicon sorbent was made for everyday use (Figure 4). However, unlike the device developed in Figure 3, this design does not have a ventilation system.

Figure 4.
Miniature design of carbon-silicon sorbent for everyday use.
As shown in Figure 4, the design of the carbon-silicon sorbent includes a system with a low-frequency mini-generator. Here, the ultrasonic mini-generator is used as a source of antibacterial agent spraying, and the solution is sprayed through the carbon-silicon sorbent onto the environment. The generation time of antibacterial agent spraying depends on the amount of solution contained in the container. In particular, the productivity of the work shift was from 4 to 10 h.
2.4. Selected Bacterial Strains
To determine the antibacterial activity of the obtained tablet forms of the sorbent, the 2 bacterial strains described below were used (Table 1). Considering that the genera of bacteria Bacillus and Pseudomonas are very widespread in the environment, water, soil, air, and food products and are both extremely resistant to stress factors and highlight adaptable to different conditions, these strains are optimal for testing the sorbent for antibacterial properties. Bacillus paramycoides and Pseudomonas koreensis, isolated from the soil, are active strains since they participate in many processes in the rhizosphere, which in turn shows them as PGPB bacteria with great potential in agriculture [30]. Pure bacterial colonies were subpassaged into a sterile liquid nutrient medium to obtain a daily culture and placed in a thermoshaker with a temperature of 35 °C and 150 rpm for 24 h. After growth, optical density was detected using an APEL PD-303 spectrophotometer. Then, 10 µL of liquid medium was cultured by the Drygalsky seeding method on a solid nutrient medium MPA in Petri dishes to form a continuous lawn, with the tablets placed in the center. After seeding, Petri dishes were incubated in a thermostat for 24 h with a temperature regime of 35 °C.

Table 1.
Macro- and micromorphological characteristics of identified bacterial strains from the museum culture.
3. Results and Discussion
3.1. Biological Hazard Analysis
One of the dangerous and harmful factors of work is biological, i.e., the appearance of microorganisms that can cause not only infectious diseases, but also a decrease in general immunity and, as a consequence, an increase in susceptibility to household infections [31].
Many researchers have studied the influence of microbial factors on humans, the development of preventive measures, and personal protective equipment [32].
However, at present, the degree of danger caused by contact with microorganisms for various industries has not been fully determined. Microbial contamination and species composition of the microbiota of the premises of various enterprises, which cause an increase in susceptibility to diseases and a decrease in productivity and labor efficiency, have not been sufficiently studied. Issues of sanitary and hygienic treatment of production facilities depending on the degree of danger of the microbial factor have also not been sufficiently studied [33].
3.2. Dust Particle Analysis
Coarse dispersed systems (carpet dust or organic dust, ash and coal dust) were studied using SEM, as shown in Figure 5.

Figure 5.
Particle size of (a) coal and (b) organic dust under a microscope.
Visual measurements were used to determine the fractions of specific dust agglomerates and the percentage of their highest content relative to other fractions. Analytical calculations were carried out to determine the dust particle size distribution function. Particle size distributions can be represented by the following relationship Equation (1) [7,14]:
where ξ is the specific content of agglomerates with dimensions dh
lg σh—standard deviation
lg (dh/dm) is the logarithm of the ratio of particles to the mean or median value.
The integral curve of the value with the particle distribution can be transformed by the following expression Equation (2):
If we express the values of the logarithms through , then Equation (2) is transformed into Equation (3):
Having carried out calculations of the analytical functions of particle distribution, we obtain a mathematical calculation board for air purification systems, which will allow automation and selection of time parameters for filter change in purification filters.
Taking the median value of particles equal to 5 µm, we obtain the particle size distribution, which is given in Table 2.

Table 2.
Particle distribution by dust type for calculating filter replacement intervals in air purification systems.
As can be seen from Table 2, organic dust of 2.5 µm in size is distributed up to 70.5 cm of specific distribution in a separate space; n, ash, and coal, having more massive particles, can have from 40.5 to 60.4 cm of specific distribution, respectively.
3.3. Efficiency of Dust Capture
As shown by the data in Figure 1 and Table 1, the average size of dust particles varies from 0.65 to 150 microns. In ash and coal dust, 100% of the particles are larger than 10 microns. Depending on humidity, temperature, and atmospheric rarefaction, air polluting particles can differ in their degree of dispersion, that is, in the size of the particles; this factor is facilitated by the agglomeration of impurities. Passing dust through a stand with a fabric filter showed 100% retention of dust with a size greater than 15 microns. The efficiency of catching organic dust varies from 74% to 98%, depending on the dispersion of particles. The results obtained are summarized in Table 3.

Table 3.
Efficiency of capturing air pollutant particles depending on their size and dispersion.
To identify the dispersed composition of solid pollutants, an analysis of the fractional composition of N air pollutants was performed using on the d-dispersion of dust particles. The fraction was taken as the relative share of particles whose sizes were in a certain range of values, adopted as the lower and upper limits.
Data on determining dust dispersion from fractional distribution are presented in Figure 6.

Figure 6.
Particle dispersion depending on from the fractional composition.
As can be seen from Figure 4, depending on the conditions, humidity, cohesion, and agglomeration in a single volume of up to 1 L, dust particles can have different particle dispersion.
In particular, the median ash dust with a dispersion of 10 μm can reach 4% of the total, while coal dust is mainly concentrated at a dispersion of 20 μm and makes up 5% of the total. Organic dust, depending on the nature of its origin, has a maximum of 3.5% at a dispersion of 15 μm.
The different dispersion of ash and coal dust can also be explained by the different nature of wettability: coal dust is practically not wetted, while ash dust is completely wetted at a moisture concentration in the air from 0.2 to 1% by volume.
One of the important factors in dust collection and air purification is the physical and chemical component of dust; specifically, the dispersion composition directly determines the speed of deposition of dust particles, and data on dust settling, specifically the speed of its settling, depends on the specific gravity of the dust-forming material and the shape of the dust particles.
Experiments were conducted to determine the rate of deposition of dusts of various natures, from organic to dust from gunpowder gases, and dust containing iron oxides from sharpening machines.
3.4. Sedimentation Rate
Data on the rate of dust settling depending on the particle size are summarized in Table 4.

Table 4.
Sedimentation rate of different dust types based on particle dispersion.
As shown in Table 4, a linear relationship between dispersion and sedimentation rate is observed in all samples. The higher the dispersion of dust particles, the higher the sedimentation rate of particles.
3.5. Material Characterization of Activated Carbon from Rice Husk
During the study, activated carbon samples were synthesized from rice husk. The size of the crushed particles of carbonized rice husk ranged from several to tens of micrometers, comparable to the size of the powdered binder, i.e., carboxymethyl cellulose (CMC). The monoliths had a cylindrical shape with adjustable diameter and length. The cross-section was uniformly distributed with square-shaped lotus-root-like holes. In addition to the straight millimeter-sized channels in the lotus-root-type monolith, there were numerous macro-, meso-, and micropores in the channel walls, which were crucial for adsorption. After activation treatment, the volume of mesopores and micropores increased more than twofold (Table 5). This indicated that alkaline activation was quite effective for carbon derived from rice husk, which could be attributed to the presence of siliceous materials in rice husk that were reactive to alkalis. Overall, it can be expected that the monolith obtained from biomass-derived carbon with a hierarchical porous structure will become a promising adsorbent.

Table 5.
Pore volume of monoliths after carbonization and activation.
The surface characteristics and porous structure of the material were studied using sorbtometry with nitrogen as an adsorbate. The tests were performed at a temperature of 77.3 K (−195.85 °C) using the static volumetric analysis method. The results of the surface area analysis calculated by different methods show significant variation. The BET method (multipoint) gave a value of 417.10 m2/g, while the single-point BET (at a relative pressure of P/P0 = 0.10003) showed 391.75 m2/g. The Langmuir method demonstrated the largest surface area of 650.01 m2/g, which indicates a high adsorption capacity of the material. The t-plot analysis revealed the contribution of micropores to the total surface area, which was 105.06 m2/g, and the external surface was determined to be 312.04 m2/g. Thus, the BET model data are considered more realistic for describing the heterogeneous structure of the material. Analysis of the porous structure of the material revealed that the total pore volume at a relative pressure of P/P0 = 0.9969 is 0.9489 mL/g. The BJH (Barrett–Joyner–Halenda) method showed that the pore volume during desorption (in the range of 1.9–43.1 nm) is 0.9508 mL/g, and during adsorption (in the range of 1.8–76.8 nm) is 0.9630 mL/g. The t-plot method determined the micropore volume as 0.0542 mL/g, while the H-K and DR methods revealed values of 0.1599 mL/g and 0.1564 mL/g, respectively. The DFT method showed the micropore volume (up to 2.07 nm) to be 0.1813 mL/g, and the total pore volume (up to 78.06 nm) was 0.7963 mL/g. Most of the volume is accounted for by the mesoporous structure, but the proportion of micropores is also significant, which is confirmed by the DFT and DR methods. The average pore size calculated by different methods shows the predominance of mesopores. The 4 V/A (BET) method gave a value of 9.10 nm, and the BJH methods for desorption and adsorption showed 9.00 nm and 9.34 nm, respectively. The MK-Plate method, which estimates the interlayer distance, determined the average pore size as 11.16 nm. At the same time, the Horvath–Kavazoic (H-K) method revealed the presence of micropores with a median diameter of 0.89 nm, indicating the presence of a significant number of narrow pores [34].
The study of the adsorption isotherm showed a typical S-shaped profile characteristic of mesoporous materials. As the relative pressure increases, an increase in the amount of sorbed nitrogen is observed, which reaches a maximum value of 613.47 mL/g at P/P0 = 0.9969. This result confirms the presence of a well-developed pore system with high adsorption capacity.
The data obtained confirm that the studied material has a high specific surface area and a developed mesoporous structure with a noticeable contribution of micropores, Figure 7. These characteristics make it promising for use in gas and liquid purification processes, as well as in sorption technologies that require materials with a high effective surface area.

Figure 7.
(A) Nitrogen adsorption–desorption isotherm (B) Adsorption data and BET linear plot.
3.6. Evaluation of Antibacterial Activity
To evaluate the antibacterial effect of a multichannel filter impregnated with iodine or Lugol’s solution, it is necessary to conduct a comprehensive analysis, including microbiological studies. These studies will help determine the effectiveness of the filter in destroying or delaying pathogenic microorganisms. Bacteria that are often found in the air and are potential pathogens were selected to test the antibacterial activity of the filter [35].
Powdered sorbent samples were converted into tablet form for ease of handling during further experiments using a hydraulic press.
A 0.5 g sample of powdered sorbent was used for all samples and subjected to 10 atmospheric pressure for 5 min. As a result, sorbent tablets (size 0.5 mm) were obtained (Figure 8).

Figure 8.
Sorbent tablets obtained using a press.
To determine the antibacterial activity of the tablet forms of the sorbent against the strains of «Bacillus paramycoides» and «Pseudomonas koreensis», a test method for the diffusion of the substance through a solid nutrient medium was used. In total, 10 μL of the liquid bacterial culture were distributed onto Petri dishes with a solid nutrient medium MPA (meat-peptone agar) using the Drygalski seeding method. This made it possible to create a «continuous lawn» of bacteria on the surface of the nutrient medium. The tablet forms of the sorbent were placed in the center of the Petri dishes with the seeded bacteria. The tablets represent the tested form of the substance, which should exhibit antibacterial properties. Petri dishes with the sorbent tablets were incubated in a thermostat at a temperature of 35 °C for 24 h. This mode was chosen since it corresponds to the optimal temperature for the growth of the studied bacteria.
These results provide valuable insights that can be utilized to optimize the composition of the sorbent to enhance its antibacterial properties. Such optimization is crucial for applications requiring materials that offer a high degree of protection against bacterial contamination. By tailoring the sorbent composition based on these findings, it is possible to improve its efficiency and broaden its potential use in areas such as medical devices, water purification systems, and food packaging. In this study, bacterial cultures were grown in a thermostat on a solid medium with the addition of tablets at varying concentrations to evaluate their antibacterial properties. The results demonstrated that variants 2 and 3 exhibited significant antibacterial activity, effectively inhibiting bacterial growth. Conversely, variants 1 and 4 did not display any antibacterial activity under the same conditions. This distinction highlights the importance of specific compositional factors in determining the antibacterial efficacy of the sorbent. These findings serve as a foundation for further research to refine and enhance the sorbent’s properties for targeted applications.
Optical density bacteria with three repetitions after incubation in liquid medium for 24 h showed the following data, confirming that the bacteria were seeded in equal concentrations:
- -
- Bacillus paramycoides 0.125
- -
- Pseudomonas koreensis 0.137
Below is a table with illustrations of the antibacterial activity of different sorbents on a solid medium (Table 6).

Table 6.
Drawings of sorbents on a solid nutrient medium with bacteria.
4. Conclusions
The developed carbon-silicon sorbents demonstrated high efficiency in capturing various types of dust and particles in the airflow, as well as partial antibacterial activity against Bacillus paramycoides and Pseudomonas koreensis. Particle size plays a crucial role in the mechanisms of pollutant capture. Analysis of air pollutants revealed that different types of dust exhibit varying dispersion fractions, emphasizing the importance of optimizing the carbon-silicon sorbent for diverse environmental conditions and particle size distributions [30]
Further analysis confirmed the high efficiency of these sorbents in capturing organic dust. Depending on particle dispersion, the filtration efficiency ranged from 74% to 98%, demonstrating their potential use in environments with significant fine dust pollution. These findings highlight the viability of carbon-silicon filters for air purification in industrial and residential settings.
To evaluate their antibacterial properties, tablet forms of carbon-silicon sorbents were tested against Bacillus paramycoides and Pseudomonas koreensis. The study yielded the following results:
- Samples 1 and 4 exhibited no antibacterial activity, possibly due to insufficient concentrations of active substances.
- Sample 3 displayed initial antibacterial activity, but the concentration of the active component was inadequate to completely suppress bacterial growth.
- Sample 2 demonstrated the highest antibacterial activity, suggesting its potential for microbial inhibition in air filtration applications.
These variations in antibacterial performance highlight the importance of bacterial adaptability. Microorganisms, particularly members of the Pseudomonas genus, are known for their metabolic versatility. Their highly plastic genome enables rapid genetic rearrangement via horizontal gene transfer, allowing them to degrade a wide range of xenobiotics and survive in contaminated or nutrient-limited environments [36,37]. Similarly, Bacillus paramycoides exhibits significant adaptability through endospore formation, enabling survival under extreme environmental stressors, such as temperature fluctuations, desiccation, and toxic compounds [38]. Recent genomic analyses have further identified unique gene clusters associated with stress response and metabolic flexibility in this species, reinforcing its resilience in challenging ecological niches [39].
Understanding these bacterial adaptation mechanisms is crucial for optimizing the antibacterial properties of carbon-silicon sorbents. To enhance their effectiveness, adjustments in composition, increased concentrations of active antibacterial components, and optimized distribution within the material are necessary.
Beyond antibacterial performance, the structural and functional properties of our plant-based carbon material provide additional insights into its potential applications. The Brunauer–Emmett–Teller (BET) surface area is a critical parameter for adsorption-based applications. Jatinder et al. reported that activated carbons derived from agricultural waste typically exhibit BET surface areas in the range of 250–300 m2/g. In contrast, our material demonstrated a significantly higher BET surface area of 417 m2/g, indicating enhanced adsorption capacity beneficial for air filtration and pollutant capture [40].
In addition to surface area, pore structure plays a crucial role in determining adsorption efficiency. Conventional carbon nanofibers possess a well-defined micro-mesoporous architecture, facilitating both high adsorption and efficient diffusion of contaminants [41]. Our plant-based carbon material exhibits a similar microporous structure with a substantial proportion of mesopores, which enhances airflow while maintaining effective contaminant retention. This duality offers a competitive advantage in applications requiring both high filtration efficiency and minimal pressure drop.
Overall, these comparisons emphasize that, while our plant-based carbon material offers significant advantages—such as high surface area, eco-friendly production, and sustainable economic impact—further optimization is required. By refining its formulation, we can enhance its antibacterial properties and expand its practical applications.
Based on these findings, the developed carbon-silicon sorbents exhibit strong potential for dual-purpose use in air filtration and microbial control. Sample 2, which demonstrated the best antibacterial results, is particularly promising for air purification systems. This unique combination of dust filtration and antibacterial action makes it well-suited for environments requiring strict air quality control, such as healthcare facilities, laboratories, and high-occupancy buildings. Continued optimization could further enhance its functionality and broaden its application in real-world settings.
Author Contributions
Conceptualization, A.M. and A.K.; methodology, D.B.; validation, M.T., Z.K. and D.M.; writing—original draft preparation, A.M. and A.K.; writing—review and editing, M.T.; project administration, D.B. and M.T.; All authors have read and agreed to the published version of the manuscript.
Funding
This research is funded by the Science Committee of the Ministry of Science and Higher Education of the Republic of Kazakhstan (Grant No. AP19676747).
Data Availability Statement
The datasets used and/or analyzed during the current study available from the corresponding author Alibek Mutushev on reasonable request.
Conflicts of Interest
There is no conflict of interest.
Abbreviations
The following abbreviations are used in this manuscript:
| CS | Carbon-silicon sorbents |
| CMC | carboxymethyl cellulose |
| PAH | aromatic polycyclic hydrocarbons |
References
- Wu, R.; Shanbhag, S.; Selvaganapathy, P.R. Efficient, Breathable, and Compostable Multilayer Air Filter Material Prepared from Plant-Derived Biopolymers. Membranes 2023, 13, 380. [Google Scholar] [CrossRef] [PubMed]
- Souzandeh, H.; Wang, Y.; Netravali, A.; Zhong, W. Towards Sustainable and Multifunctional Air-Filters: A Review on Biopolymer-Based Filtration Materials. Polym. Rev. 2019, 59, 651–686. [Google Scholar] [CrossRef]
- Sawatdee, S.; Botalo, A.; Noinonmueng, T.; Posoknistakul, P.; Intra, P.; Pongchaikul, P.; Charnnok, B.; Chanlek, N.; Laosiripojana, N.; Wu, K.C.W.; et al. Fabrication of multilayer cellulose filters isolated from natural biomass for highly efficient air filtration for replacement of synthetic HEPA filters. Process Saf. Environ. Prot. 2025, 194, 216–230. [Google Scholar] [CrossRef]
- Weschler, C.J.; Shields, H.C.; Naik, D.V. An evaluation of activated carbon filters for the control of ozone, sulfur dioxide, and selected volatile organic compounds. In Proceedings of IAQ 92: Environments for People; ASHRAE: Atlanta, GA, USA, 1993. [Google Scholar]
- Chiang, Y.C.; Chiang, P.C.; Huang, C.P. Effect of pore structure and temperature on VOC adsorption on activated carbon. Carbon 2001, 39, 523–534. [Google Scholar] [CrossRef]
- Franco, S.A.C.; Correa, M.A.; David Aguiar, G.; Gómez, L.M.; Colorado, H.A. Characterization and Source Apportionment of Ion and Metals in PM10 In an Urbanized Valley in The American Tropics Using Principal Component Analysis and Positive Matrix Factorization. Eng. Sci. 2024, 30, 1154. [Google Scholar] [CrossRef]
- Burenin, V.V. Protection of atmospheric air from industrial dust, toxic vapors and gases. Ecol. Ind. Russ. 2004, 9, 25–29. [Google Scholar]
- Kujundzic, E.; Zander, D.A.; Hernandez, M.; Angenent, L.T.; Henderson, D.E.; Miller, S.L. Effects ofceiling-mounted HEPA-UV air filters on airborne bacteria concentrations in an indoor therapy pool building. Kuhn J. Air Waste Manag. Assoc. 2005, 55, 210–218. [Google Scholar] [CrossRef] [PubMed][Green Version]
- Popova, A.S. Methods cleaning And disinfection air V systems ventilation. Bull. Master’s Degree Programs 2021, 112, 102–109. [Google Scholar]
- Roy, A.; Mishra Ch Jain, S.; Solanki, N. A review of general and modern methods of air purification. J. Therm. Eng. 2019, 5, 22–28. [Google Scholar] [CrossRef]
- Bastani, A.; Lee, C.-S.; Haghighat, F.; Flaherty, C.; Lakdawala, N. Assessing the performance of air cleaning devices—A full-scale test method. Build. Environ. 2010, 45, 143–149. [Google Scholar] [CrossRef]
- Kalmykov, A.V. Current state of the theory of centrifugal dust separation. In Aerodynamics of Heat and Mass Transfer in Dispersed Flows; Nauka: Moscow, Russia, 1967; pp. 80–89. [Google Scholar]
- Vetoshkin, A.G. Theoretical Foundations of Environmental Protection: A Tutorial; Vetoshkin, A.G., Ed.; Higher School of Economics: Moscow, Russia, 2008; p. 397. [Google Scholar]
- EN 1822:2009; High Efficiency Air Filters—Part 1: Classification, Performance Testing, Marking and Product Documentation. European Committee for Standardization: Brussels, Belgium, 2009.
- Niza, I.L.; Bueno, A.M.; da Silva, M.C. Evandro Eduardo Broday aAir quality and ventilation: Exploring solutions for healthy and sustainable urban environments in times of climate change. Results Eng. 2024, 24, 103157. [Google Scholar] [CrossRef]
- Lin, C.; Wu, L.; Xia, H.; Zhen, M.; Shen, C.; Zhu, J.; Li, X. Characteristics of the thermal environment, air quality, and passenger comfort in the underground transfer space of metro stations in Beijing. J. Build. Eng. 2022, 59, 105093. [Google Scholar] [CrossRef]
- Drozdov, S.G.; Garin, N.S.; Dzhindoyan, L.S.; Tarasenko, V.M. Fundamentals of Safety Engineering in Microbiological and Virological Laboratories; Medicine: Moscow, Russia, 1987; p. 265. [Google Scholar]
- Lavanya, P.; Reddy, I.V.S.; Selvakumar, V. Long Range Radio Technology Implementation on Internet of Things to Detect Particulate Matter at the Community Level and Prediction Using Machine Learning Based Approach. Eng. Sci. 2024, 29, 1119. [Google Scholar] [CrossRef]
- Nuraly, A.; Mutushev, A.; Tuleibayeva, A.; Gonzalez-Leal, J.M. Experimental research on optimizing carbon materials for filtration applications in medicine. Carbon Trends 2024, 15, 100338. [Google Scholar] [CrossRef]
- Nuraly, A.; Akhnazarov, S.; Apaydin-Varol, E.; Amzeyeva, U.; Mutushev, A. Comparative analysis of hemosorbents obtained at different modes. Rev. Mater. 2020, 25, e-12893. [Google Scholar] [CrossRef]
- Chen, M.; Hu, Q.; Wang, X.; Zhang, W. A review on recent trends of the antibacterial nonwovens air filter materials: Classification, fabrication, and application. Sep. Purif. Technol. 2024, 330 Pt B, 125404. [Google Scholar] [CrossRef]
- Southern, A.P.; Anastasopoulou, C.; Jwayyed, S. Iodine Toxicity. In StatPearls [Internet]; StatPearls Publishing: Treasure Island, FL, USA, 2024. [Google Scholar] [PubMed]
- Bigliardi, P.L.; Alsagoff, S.A.L.; El-Kafrawi, H.Y.; Pyon, J.-K.; Wa, C.T.C.; Villa, M.A. Povidone iodine in wound healing: A review of current concepts and practices. Int. J. Surg. 2017, 44, 260–268. [Google Scholar] [CrossRef] [PubMed]
- Al-Attabi, R.; Morsi, Y.; Schütz, J.A.; Cornu, D.; Maghe, M.; Dumée, L.F. Flexible and reusable carbon nano-fibre membranes for airborne contaminants capture. Sci. Total Environ. 2021, 754, 142231. [Google Scholar] [CrossRef] [PubMed]
- Park, K.T.; Hwang, J. Filtration and inactivation of aerosolized bacteriophage MS2 by a CNT air filter fabricated using electro-aerodynamic deposition. Carbon 2014, 75, 401–410. [Google Scholar] [CrossRef]
- Kim, S.; Chung, J.; Lee, S.H.; Yoon, J.H.; Kweon, D.-H.; Chung, W.-J. Tannic acid-functionalized HEPA filter materials for influenza virus capture. Sci. Rep. 2021, 11, 979. [Google Scholar] [CrossRef]
- Chupalov, V.S. Fundamentals of assessing the efficiency of air filters. In Engineering Systems. St. Petersburg; AVOK North-West: St.-Petersburg, Russia, 2008; pp. 14–22. [Google Scholar]
- Suleimenova, M.; Zharylkan, S.; Mekenova, M.; Mutushev, A.; Azat, S.; Tolepova, A.; Baimenov, A.; Satayeva, A.; Tauanov, Z. Fusion-Assisted Hydrothermal Synthesis of Technogenic-Waste-Derived Zeolites and Nanocomposites: Synthesis, Characterization, and Mercury (II) Adsorption. Int. J. Mol. Sci. 2023, 24, 11317. [Google Scholar] [CrossRef]
- Daulbayev, C.; Nursharip, A.; Tauanov, Z.; Busquets, R.; Baimenov, A. Mechanisms of mercury removal from water with highly efficient MXene and silver-modified polyethyleneimine cryogel composite filters. Adv. Compos. Hybrid Mater. 2024, 7, 139. [Google Scholar] [CrossRef]
- Minuț, M.; Diaconu, M.; Roșca, M.; Cozma, P.; Bulgariu, L.; Gavrilescu, M. Screening of Azotobacter, Bacillus and Pseudomonas Species as Plant Growth-Promoting Bacteria. Processes 2023, 11, 80. [Google Scholar] [CrossRef]
- Bourdichon, F.; Betts, R.; Dufour, C.; Fanning, S.; Farber, J.; McClure, P.; Stavropoulou, D.A.; Wemmenhove, E.; Zwietering, M.H.; Winkler, A. Processing environment monitoring in low moisture food production facilities: Are we looking for the right microorganisms? Int. J. Food Microbiol. 2021, 356, 109351. [Google Scholar] [CrossRef]
- Bui, T. The Influence of Microorganisms on Human Health. Bachelor’s Thesis, Portland State University, Portland, OR, USA, 2023; p. 1384. [Google Scholar]
- Carrascosa, C.; Raheem, D.; Ramos, F.; Saraiva, A.; Raposo, A. Microbial Biofilms in the Food Industry-A Comprehensive Review. Int. J. Environ. Res. Public Health 2021, 18, 2014. [Google Scholar] [CrossRef] [PubMed]
- Li, Y.; Biisembaev, M.; Gong, Q.; Aknazarov, S.; Lu, F.; Huang, Y.; Zhao, X.; Du, K.; Bai, J.; Gan, J.; et al. Preparation of Lotus Root-Type Monolithic-Activated Carbons with an Hierarchical Pore Structure from Rice Husks and Their Adsorption of Vitamin B12. ACS Omega 2019, 4, 18930–18935. [Google Scholar] [CrossRef] [PubMed]
- Singh, H.; Kumar, S.; Arya, A. Evaluation of antibacterial, antioxidant, and anti-inflammatory properties of GC/MS analysis of extracts of Ajuga. integrifolia Buch.-Ham. leaves. Sci. Rep. 2024, 14, 16754. [Google Scholar] [CrossRef] [PubMed]
- Jiménez, J.I.; Miñambres, B.; García, J.L.; Díaz, E. Genomic analysis of the aromatic catabolic pathways from Pseudomonas putida. Microbiol. Mol. Biol. Rev. 2002, 66, 230–262. [Google Scholar] [CrossRef] [PubMed]
- Silby, M.W.; Winstanley, C.; Godfrey SA, C.; Levy, S.B.; Jackson, R.W. Pseudomonas genomes: Diverse and adaptable. FEMS Microbiol. Rev. 2011, 35, 652–680. [Google Scholar] [CrossRef] [PubMed]
- Nicholson, W.L.; Munakata, N.; Horneck, G.; Melosh, H.J.; Setlow, P. Resistance of Bacillus endospores to extreme terrestrial and extraterrestrial environments. Microbiol. Mol. Biol. Rev. 2000, 64, 548–572. [Google Scholar] [CrossRef]
- Liu, Y.; Zhang, X.; Zhao, Y. Bacillus paramycoides sp. nov., a novel species isolated from industrial effluent. Int. J. Syst. Evol. Microbiol. 2017, 67, 2070–2075. [Google Scholar]
- Ratana, J.K.; Kaura, M.; Adirajua, B. Synthesis of activated carbon from agricultural waste using a simple method: Characterization, parametric and isotherms study. Mater. Today Proc. 2018, 5, 3334–3345. [Google Scholar] [CrossRef]
- Mao, M.; Deng, J.; Yan, T.; Shen, J.; Zhang, J.; Shi, L.; Zhang, D. Fe-, N-Embedded Hierarchically Porous Carbon Architectures Derived from FeTe-Trapped Zeolitic Imidazolate Frameworks as Efficient Oxygen Reduction Electrocatalysts. ACS Sustain. Chem. Eng. 2019, 7, 19268–19276. [Google Scholar] [CrossRef]
Disclaimer/Publisher’s Note: The statements, opinions and data contained in all publications are solely those of the individual author(s) and contributor(s) and not of MDPI and/or the editor(s). MDPI and/or the editor(s) disclaim responsibility for any injury to people or property resulting from any ideas, methods, instructions or products referred to in the content. |
© 2025 by the authors. Licensee MDPI, Basel, Switzerland. This article is an open access article distributed under the terms and conditions of the Creative Commons Attribution (CC BY) license (https://creativecommons.org/licenses/by/4.0/).